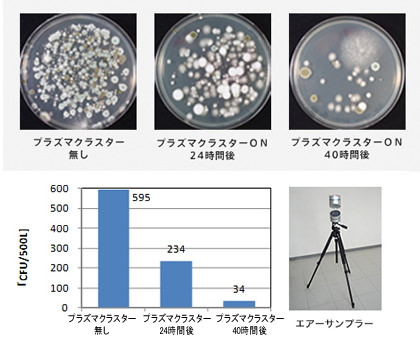
導入までの流れ

ソリューション
トータルサポート&サービス
お客様の環境に合わせたプランニング、設置工事、メンテナンスまでトータルでサポートします。
*当ページに掲載されている図面や写真は導入先の実例です。状況により結果は異なります。
■ 設置プラン(無償)
●設置プランの例
図面に基づき、各空間の状況に適した機種、台数をご提案致します。
■ イオン濃度シミュレーション(有償)
●イオン濃度の分布の例
実際にプラズマクラスター機器を設置した場合、お部屋のイオン濃度がどれくらいになるか、シミュレーションを行います。
■ 浮遊菌測定(有償)
プラズマクラスター機器を設置する前後での浮遊菌の数を測定し、効果を検証します。
写真は導入までの流れをご説明するためのものであり、プラズマクラスターの効能を保証するものではありません。
■ 導入後も安心の保守サービスプラン(有償)
業種別ソリューション
様々な業種に応じたプラズマクラスターのソリューションをご紹介します。













